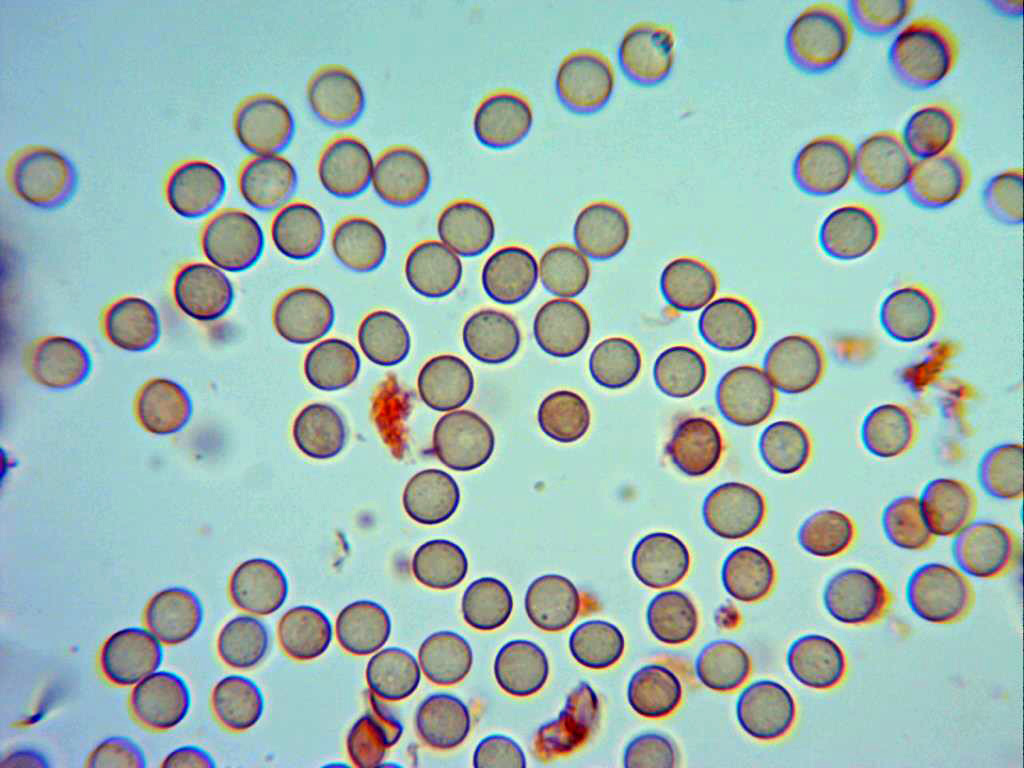

- Foro
- Foros sobre Micología de fungipedia
- Consultas de micología
- Stemonitis axifera (Bull). T. Macbr.
×
Cuando realices una consulta fíjate bien en quien te responde para valorar la verdadera capacidad de respuesta de dicha persona basándote en sus conocimientos. Nunca te fíes ciegamente de ninguna respuesta que te den, ANTES DE CONSUMIR UN EJEMPLAR DESCONOCIDO consulta siempre con un micólogo que pueda ver físicamente el ejemplar, llevale todos los ejemplares que vayas a consumir porque puede que dos setas que te parezcan iguales no lo sean. Para facilitar una identificación es recomendable especificar detalles del hábitat, tamaño (la cámara engaña), color de las láminas de maduras etc.
 Stemonitis axifera (Bull). T. Macbr.
Stemonitis axifera (Bull). T. Macbr.
- Héctor
-
 Autor del tema
Autor del tema
- Fuera de línea
- Moderador
-

Menos
Más
- Mensajes: 1022
- Gracias recibidas: 1026
8 años 9 meses antes #95117
por Héctor
Stemonitis axifera (Bull). T. Macbr. Publicado por Héctor
Muy buenas a todos,
es la pirmera vez que hacemos un mixo de este tipo, la verdad que no dispongo de una buena clave para identificarlas, pero creo que es esta nuestra especie.
Van las fotos macro
y ahora con las micro, espero que sean suficientes, porque no sé muy bien qué mirar o si me dejo algún elemento importante
la columnela
la redecilla
y esporas, con verrugas que cuesta ver, bastante pequeñas
A ver si os parece que vamos bien encaminados.
Un saludo
es la pirmera vez que hacemos un mixo de este tipo, la verdad que no dispongo de una buena clave para identificarlas, pero creo que es esta nuestra especie.
Van las fotos macro
y ahora con las micro, espero que sean suficientes, porque no sé muy bien qué mirar o si me dejo algún elemento importante
la columnela
la redecilla
y esporas, con verrugas que cuesta ver, bastante pequeñas
A ver si os parece que vamos bien encaminados.
Un saludo
Por favor, Identificarse para unirse a la conversación.
- Josep Torres
-

- Fuera de línea
- Moderador
-

Menos
Más
- Mensajes: 8746
- Gracias recibidas: 8379
8 años 9 meses antes #95118
por Josep Torres
Respuesta de Josep Torres sobre el tema Stemonitis axifera (Bull). T. Macbr.
Bravo, Héctor, mi más sincera enhorabuena, mejoras a pasos agigantados con el micro. Una micro excelente, precisamente esta es la primera Stemonitis que pasé por el micro. El tamaño esporal que nos indicas está ligeramente por encima del que obtuve en mis mediciones, pero entra bien dentro de la posible variabilidad de la especie. Para mi que la tienes bien identificada. El tamaño esporal de la Stemonitis axifera está por debajo del de sus posibles confusiones. Te dejo un enlace de la especie que a mí personalmente me sirvió de mucha ayuda para identificar a esta y las otras tres Stemonitis que ya he pasado por el micro.
www.discoverlife.org/mp/20q?search=Stemonitis+axifera
Te dejo también un par de imágenes de la microscopía que realicé a la Stemonitis axifera.
Un abrazo
Capilicio a 400 aumentos.
Esporas muy ligeramente y suavemente verrucosas y en mis mediciones de entre 5,5 y 6,7 micras.
www.discoverlife.org/mp/20q?search=Stemonitis+axifera
Te dejo también un par de imágenes de la microscopía que realicé a la Stemonitis axifera.
Un abrazo
Capilicio a 400 aumentos.
Esporas muy ligeramente y suavemente verrucosas y en mis mediciones de entre 5,5 y 6,7 micras.
Por favor, Identificarse para unirse a la conversación.
- Josep Torres
-

- Fuera de línea
- Moderador
-

Menos
Más
- Mensajes: 8746
- Gracias recibidas: 8379
8 años 9 meses antes #95119
por Josep Torres
Respuesta de Josep Torres sobre el tema Stemonitis axifera (Bull). T. Macbr.
Muy parecida es la Stemonitis splendens var. splendens, con una morfología esporal idéntica pero con un tamaño esporal mayor, te dejo también el enlace de esta y una imagen mía de las esporas con las mediciones.
www.discoverlife.org/mp/20q?search=Stemonitis+splendens
Las medidas de estas en mi caso de entre 6,7 y 8,1 micras.
Creo que la que nos muestras está más acorde con la Stemonitis axifera tal y como nos indicas.
Un abrazo
www.discoverlife.org/mp/20q?search=Stemonitis+splendens
Las medidas de estas en mi caso de entre 6,7 y 8,1 micras.
Creo que la que nos muestras está más acorde con la Stemonitis axifera tal y como nos indicas.
Un abrazo
Por favor, Identificarse para unirse a la conversación.
- Jon Joseba Arnedo
-

- Fuera de línea
- Moderador
-

Menos
Más
- Mensajes: 3702
- Gracias recibidas: 3555
8 años 9 meses antes #95123
por Jon Joseba Arnedo
Respuesta de Jon Joseba Arnedo sobre el tema Stemonitis axifera (Bull). T. Macbr.
Que chulada de post! tanto las imágenes macro como microscópicas son de enmarcar 
De estas suelo ver unas cuantas todos los años, la semana pasada sin ir mas lejos pero..se me quedan en sp
Un abrazo
De estas suelo ver unas cuantas todos los años, la semana pasada sin ir mas lejos pero..se me quedan en sp
Un abrazo
Por favor, Identificarse para unirse a la conversación.
- Foro
- Foros sobre Micología de fungipedia
- Consultas de micología
- Stemonitis axifera (Bull). T. Macbr.
Tiempo de carga de la página: 0.116 segundos

Foro de micología